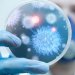
باحثون يحددون جينا يلعب دورا أساسيا باستجابة الجهاز المناعي

نجح الطب الحديث في تحويل الضوء إلى وسيلة علاجية فعالة تساعد في مواجهة طيف واسع من الأمراض والمشكلات الصحية، فيما يعرف باسم «العلاج بالضوء».
ويعتمد هذا النوع من العلاج على تعريض الجسم أو مناطق محددة منه لأنواع خاصة من الضوء وبجرعات محسوبة بعناية، بهدف تحفيز عمليات حيوية داخل الجسم أو الحد من أعراض بعض الأمراض.
وقد أثبتت الدراسات أن هذه التقنية لا تقتصر على علاج الأمراض الجلدية فحسب، بل تمتد فوائدها لتشمل تحسين الحالة النفسية، وتنظيم النوم، وتخفيف الألم، والمساهمة في علاج بعض الأمراض المناعية والسرطانية، ما جعلها تحظى باهتمام متزايد من الأطباء والباحثين حول العالم.
وفيما يلي أبرز المشكلات الصحية التي يمكن أن يسهم العلاج بالضوء في علاجها أو التخفيف من أعراضها، حسب ما نقله موقع «ويب ميد» العلمي:
البهاق
يمكن علاج البهاق بنوعين من العلاج الضوئي. الأول يعتمد على استخدام الأشعة فوق البنفسجية ضيقة النطاق، حيث يجلس المريض داخل صندوق أو مقصورة ضوئية أو يتلقى العلاج بواسطة أجهزة متخصصة، والثاني يتم فيه استخدام الأشعة فوق البنفسجية من نوع آخر (النوع أ) بالتزامن مع دواء يساعد الجلد على الاستجابة للعلاج.
كلا العلاجين الضوئيين فعال بنسبة 70 في المائة تقريباً في استعادة لون الجلد، ولكن الطريقة الثانية قد تزيد من احتمالية الإصابة بسرطان الجلد.
الصدفية
يساعد العلاج بالضوء في علاج أشكال متعددة من الصدفية، بما في ذلك الصدفية التي تصيب فروة الرأس والأظافر واليدين والقدمين.
وتعمل الأشعة الضوئية على إبطاء النمو المفرط لخلايا الجلد، وتهدئة النشاط الزائد للجهاز المناعي وتقليل الالتهاب وتخفيف الحكة والانزعاج المصاحبين للمرض.
التصلب الجلدي وتخفيف التندبات
عندما يمتد التصلب إلى الطبقات العميقة من الجلد، قد يلجأ الأطباء إلى أنواع خاصة من العلاج الضوئي القادرة على اختراق الجلد بعمق.
وتساعد هذه التقنية على تليين المناطق المتندبة والمتصلبة وتقليل الحكة وتحسين مظهر بعض البقع الجلدية الداكنة.
الاضطراب العاطفي الموسمي (SAD)
يُعد العلاج بالضوء من أشهر الوسائل المستخدمة لعلاج الاكتئاب الموسمي، الذي يظهر غالباً خلال فصول السنة التي تقل فيها ساعات التعرض للشمس.
ويستخدم المرضى مصابيح ضوئية خاصة تحاكي ضوء النهار، ما يساعد على تحسين الحالة المزاجية وتنظيم النوم وتعزيز إفراز الهرمونات المرتبطة بالشعور بالراحة النفسية.
علاج بعض حالات الاكتئاب غير الموسمي
لا يقتصر تأثير العلاج الضوئي على الاكتئاب الموسمي فقط، بل يمكن أن يُستخدم أيضاً في حالات الاكتئاب الأخرى، سواء بمفرده أو إلى جانب الأدوية الموصوفة من قِبَل الطبيب.
وتستغرق الجلسة العلاجية المعتادة نحو ثلاثين دقيقة يومياً.
مكافحة حب الشباب
يساعد العلاج بالضوء الأزرق أو الأحمر أو الضوء النبضي المكثف (IPL) في علاج حب الشباب من خلال القضاء على البكتيريا المسببة للالتهابات الجلدية وتقليل الإفرازات الدهنية الزائدة وإزالة الخلايا الميتة التي تسد المسام والحد من ظهور الرؤوس السوداء.
تخفيف الآلام المزمنة
يُمكن أن يُساعد العلاج بالضوء الأحمر، وهو نوع من العلاج يستخدم ضوءاً أحمر قصير الموجة، في تخفيف الألم الناتج عن اضطرابات الجهاز العضلي الهيكلي. يُمكن لهذا الضوء تخفيف آلام الظهر أو الرقبة، بالإضافة إلى الألم الناتج عن حالات مثل التهاب المفاصل العظمي، والتهاب المفاصل الروماتويدي، ومتلازمة النفق الرسغي، ومشاكل الأسنان.
اضطرابات النوم
يمكن للعلاج الضوئي أن يساعد على إعادة ضبط الساعة البيولوجية للجسم، خصوصاً لدى الأشخاص الذين يعانون من اضطرابات النوم أو اختلال مواعيد النوم والاستيقاظ.
علاج مرض المورفيا الجلدي
مرض المورفيا الجلدي هو مرض مناعي ذاتي نادر يتميز بفرط إفراز الكولاجين، ويسبب ظهور بقع حمراء أو بيضاء أو مناطق متصلبة وغير مؤلمة على الجلد.
وفي الحالات الشديدة التي تغطي مساحات واسعة من الجسم، قد يساعد العلاج بالأشعة فوق البنفسجية في تخفيف الأعراض وتحسين حالة الجلد.